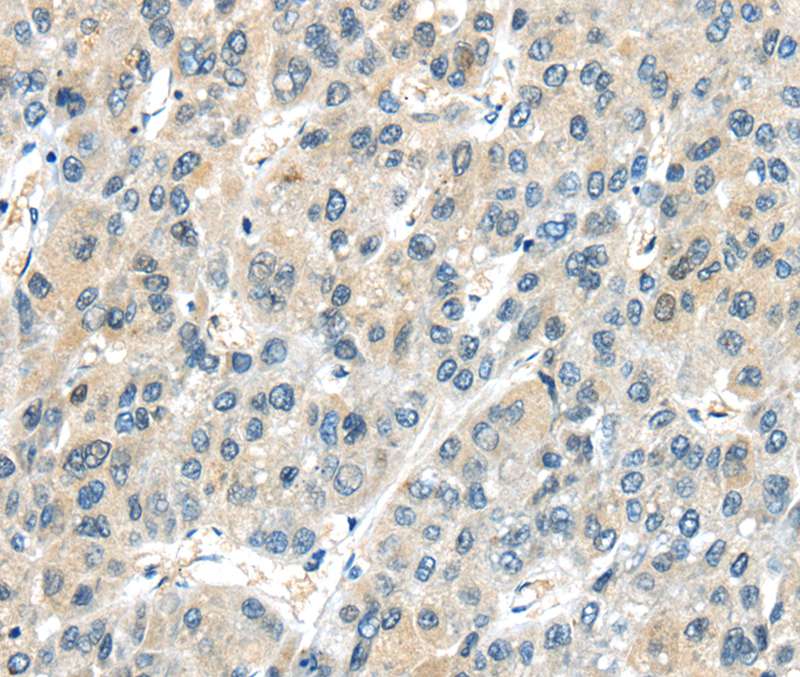

AHI1 Antibody
LS-C497387
ApplicationsWestern Blot
Product group Antibodies
TargetAHI1
Overview
- SupplierLifeSpan BioSciences
- Product NameAHI1 Antibody
- Delivery Days Customer23
- Application Supplier NoteThe predicted MW is 70kDa/120kDa/137kDa, while the observed MW by Western blot was Refer to Figures.
- ApplicationsWestern Blot
- Applications SupplierWB The predicted MW is 70kDa/120kDa/137kDa, while the observed MW by Western blot was Refer to Figures.
- CertificationResearch Use Only
- ClonalityPolyclonal
- ConjugateUnconjugated
- Estimated Purity...
- Gene ID54806
- Target nameAHI1
- Target descriptionAbelson helper integration site 1
- Target synonymsAHI-1, JBTS3, ORF1, dJ71N10.1, jouberin, abelson helper integration site 1 protein homolog, contatins SH3 and WD40 domains
- HostRabbit
- UNSPSC12352203